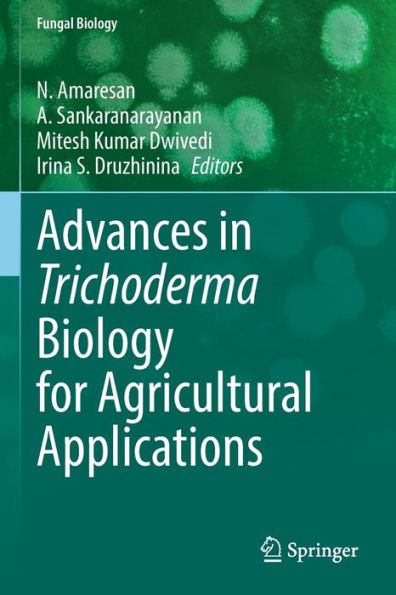
Advances In Trichoderma Biology For Agricultural Applications (Fungal Biology) - 9783030916527

1
/
of
1
Springer
Advances In Trichoderma Biology For Agricultural Applications (Fungal Biology) - 9783030916527
Advances In Trichoderma Biology For Agricultural Applications (Fungal Biology) - 9783030916527
ISBN-13: 9783030916527
Regular price
$190.78
Regular price
Sale price
$190.78
Unit price
/
per
Couldn't load pickup availability
Advances in Trichoderma Biology for Agricultural Applications covers the beneficial properties of Trichoderma in enhancing global agricultural productivity. Trichoderma are biotechnologically significant fungi, being widely used both agriculturally and industrially. In many cases Trichoderma are also a potential drug source of clinical importance. In recent years, driven by advances in genetics and genomics, research on these fungi has opened new avenues for its various applications. This book covers i) Current state of Trichoderma taxonomy, and species identification, ii) Trichoderma and plant-pathogenic fungi interactions, iii) Trichoderma interactions with plants, including rhizosphere competence of Trichoderma, antagonistic potentials, plant growth promotion, and management of various abiotic stresses in plants, iv) Practical aspects of Trichoderma commercialization in agriculture, v) Biosynthesis of metal-based nanoparticles and its application, and vi) Negative impact of Trichoderma strains in the environments. Reading this book should kindle further discussions among researchers working in fungal biotechnology, microbiology, agriculture, environmental science, forestry, and other allied subjects and thus lead to a broader scope of Trichoderma-based products and technologies. The knowledge shared in this book should also provide a warning on the potential risks associated with Trichoderma.
- | Author: N. Amaresan, A. Sankaranarayanan, Mitesh Kumar Dwivedi, Irina S. Druzhinina
- | Publisher: Springer
- | Publication Date: Jun 11, 2023
- | Number of Pages: 664 pages
- | Language: English
- | Binding: Paperback
- | ISBN-10: 3030916529
- | ISBN-13: 9783030916527
Share